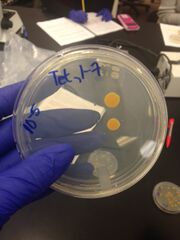

Uploads by Yasmine Yaiche
From OpenWetWare
Jump to navigationJump to search
This special page shows all uploaded files.
| Date | Name | Thumbnail | Size | Description |
|---|---|---|---|---|
| 23:57, 14 March 2015 | CRETEJUNGLEXO-image1231212124441222.jpg (file) |  |
51 KB | |
| 23:56, 14 March 2015 | CRETEJUNGLEXO-image1234343431222.jpg (file) |  |
303 KB | |
| 23:56, 14 March 2015 | CRETEJUNGLEXO-image123129909022.jpg (file) |  |
44 KB | |
| 23:55, 14 March 2015 | CRETEJUNGLEXO-image99000222.jpg (file) |  |
46 KB | |
| 23:55, 14 March 2015 | CRETEJUNGLEXO-image129931222.jpg (file) |  |
42 KB | |
| 23:54, 14 March 2015 | CRETEJUNGLEXO-image124531222.jpg (file) |  |
59 KB | |
| 23:52, 14 March 2015 | CRETEJUNGLEXO-image1098231222.jpg (file) |  |
79 KB | |
| 23:51, 14 March 2015 | CRETEJUNGLEXO-image12731222.jpg (file) |  |
48 KB | |
| 23:47, 14 March 2015 | CRETEJUNGLEXO-image12381222.jpg (file) |  |
49 KB | |
| 23:46, 14 March 2015 | CRETEJUNGLEXO-image1231224242422.jpg (file) |  |
204 KB | |
| 06:31, 5 March 2015 | CRETEJUNGLEXO-image1231222.jpg (file) |  |
345 KB | |
| 06:31, 5 March 2015 | CRETEJUNGLEXO-image1233333332.jpg (file) |  |
357 KB | |
| 06:30, 5 March 2015 | CRETEJUNGLEXO-image12322.jpg (file) |  |
207 KB | |
| 06:30, 5 March 2015 | CRETEJUNGLEXO-image1232300123.jpg (file) | 249 KB | ||
| 06:24, 5 March 2015 | CRETEJUNGLEXO-image12323123.jpg (file) |  |
249 KB | |
| 16:25, 16 February 2015 | CRETEJUNGLEXO-image09099090.jpg (file) |  |
139 KB | |
| 16:24, 16 February 2015 | CRETEJUNGLEXO-image00999.jpg (file) |  |
162 KB | |
| 16:21, 16 February 2015 | CRETEJUNGLEXO-image0909090.jpg (file) |  |
139 KB | |
| 16:16, 16 February 2015 | CRETEJUNGLEXO-image000.jpg (file) |  |
123 KB | |
| 08:13, 15 February 2015 | CRETEJUNGLEXO-image1232.jpg (file) |  |
224 KB | |
| 06:32, 15 February 2015 | CRETEJUNGLEXO-image5040.jpg (file) |  |
90 KB | |
| 05:11, 15 February 2015 | CRETEJUNGLEXO-image00.jpg (file) |  |
656 KB | |
| 05:09, 15 February 2015 | CRETEJUNGLEXO-image0.jpg (file) |  |
472 KB | |
| 04:51, 6 February 2015 | CRETEJUNGLEXO-image12.jpg (file) |  |
65 KB | |
| 04:50, 6 February 2015 | CRETEJUNGLEXO-image13.jpg (file) |  |
243 KB | |
| 04:49, 6 February 2015 | CRETEJUNGLEXO-image33.jpg (file) |  |
67 KB | |
| 04:48, 6 February 2015 | CRETEJUNGLEXO-image93.jpg (file) |  |
83 KB | |
| 04:44, 6 February 2015 | CRETEJUNGLEXO-image333.jpg (file) |  |
58 KB | |
| 04:39, 6 February 2015 | CRETEJUNGLEXO-image222.jpg (file) |  |
69 KB | |
| 04:34, 6 February 2015 | CRETEJUNGLEXO-image444.jpg (file) |  |
71 KB | |
| 04:33, 6 February 2015 | CRETEJUNGLEXO-image100.jpg (file) | |
78 KB | |
| 07:20, 26 January 2015 | CRETEJUNGLEXO-image7.jpg (file) |  |
78 KB | |
| 07:17, 26 January 2015 | CRETEJUNGLEXO-image5.jpg (file) |  |
76 KB | |
| 07:17, 26 January 2015 | CRETEJUNGLEXO-image4.jpg (file) |  |
36 KB | |
| 07:16, 26 January 2015 | CRETEJUNGLEXO-image6.jpg (file) |  |
64 KB | |
| 07:15, 26 January 2015 | CRETEJUNGLEXO-image3.jpg (file) |  |
75 KB | |
| 07:11, 26 January 2015 | CRETEJUNGLEXO-image2.jpg (file) |  |
187 KB | |
| 07:09, 26 January 2015 | CRETEJUNGLEXO-image1.jpg (file) |  |
259 KB | |
| 07:05, 26 January 2015 | CRETEJUNGLEXO - image1.JPG (file) |  |
259 KB |